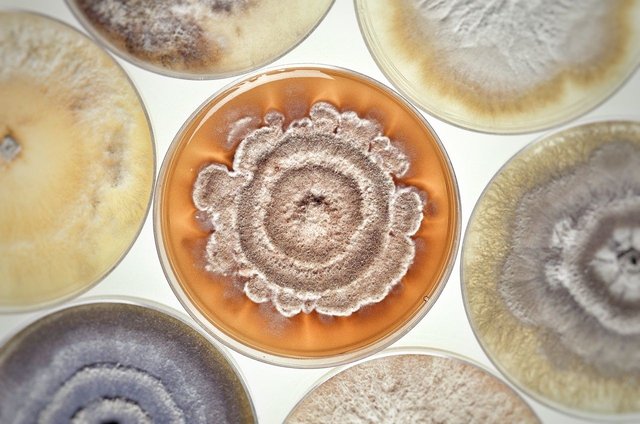

The Blockchain Is a Rudimentary Universe.
As soon as a blockchain is interacted with (let's call it an event), any and all future events retain the information of all prior events. A blockchain blossoms by not only being public and unalterable (much like the Past), but by its temporal nature.
LOL, so? What about a hard fork?
Think of it this way: mammals replaced dinosaurs as the dominant macrofauna, but that doesn't erase dinosaurs from the record. Also, if it wasn't for dinosaurs, mammals would not have developed the way they did.
Granted, a hard fork is a meteor, or a fickle god disrupting the original conditions. But the past remains, as long as there is activity in the blockchain. Dead altcoins could be seen as peephole into a universe that has already undergone heat death.
But isn't that more like the geologic record of life, broheim? Not like the universe?
I'll give you that one, duderino. If I'm going to extend this analogy, then the internet is a petri dish in a lab and blockchains are strains of bacteria. On the other hand, we could be entering a time when blockchain tech becomes the dominant method of any kind of digital interaction. If that becomes the case, my universe analogy will be more apt.
Further, if we think about smart contracts, they could be an analog of the physical laws of this cyber universe. Purely mechanical, they activate when conditions are met. They same could be said of user-created bots like we have on Steemit, external agents interacting with the blockchain.
But ...
What happens, if the internet at large is exclusively blockchain-based, and AI decentralized apps more and more begin to show characteristics of life? Right now, the smart assistants are centralized entities. Similar to Anton in the recent Silicon Valley finale, what could we expect from an AI that makes the jump into the blockchain? Will it be bound by the "physical laws" of this universe? Will it have the computational power to alter them? Will it become a little Lawnmower Man?

I can dig it!
I wish I was a developer, man. As a non-tech person, all I can do is the concepts.
RESTEEMED!!
I am not so sure the past is as immutable and unchangeable as we think. See my posts on Mandella Effect
But that's what I'm referring to!! That could easily be a parallel optimal blockchain in a close petri dish that our governing AI sidechains decided to trans-fork us into. I'm a proud E-verse origin entity, thanks! #berenstEin
Congratulations! This post has been upvoted from the communal account, @minnowsupport, by writtenbird from the Minnow Support Project. It's a witness project run by aggroed, ausbitbank, teamsteem, theprophet0, and someguy123. The goal is to help Steemit grow by supporting Minnows and creating a social network. Please find us in the Peace, Abundance, and Liberty Network (PALnet) Discord Channel. It's a completely public and open space to all members of the Steemit community who voluntarily choose to be there.
If you like what we're doing please upvote this comment so we can continue to build the community account that's supporting all members.
@writtenbird got you a 4.92% @minnowbooster upgoat, nice! (Image: pixabay.com)
Want a boost? Click here to read more!